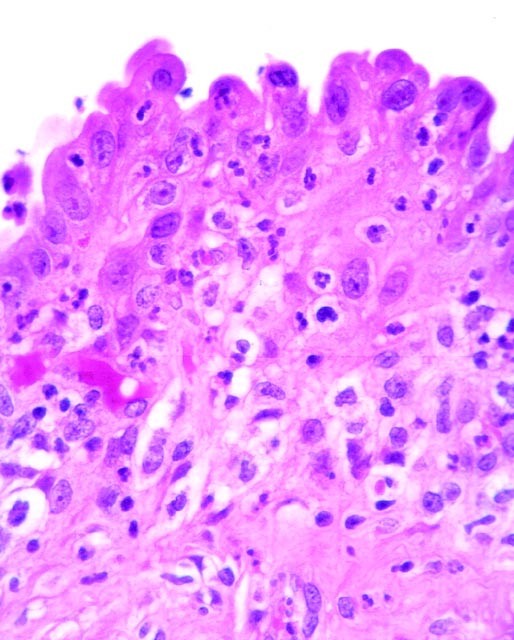
FIGURE 7

FIGURE 7
From: Metaplastic Lesions of the Extrahepatic Bile Ducts: A Morphologic and Immunohistochemical Study

Reactive atypia of the surface biliary epithelium with intraepithelial and subepithelial neutrophils.
From: Metaplastic Lesions of the Extrahepatic Bile Ducts: A Morphologic and Immunohistochemical Study
Reactive atypia of the surface biliary epithelium with intraepithelial and subepithelial neutrophils.